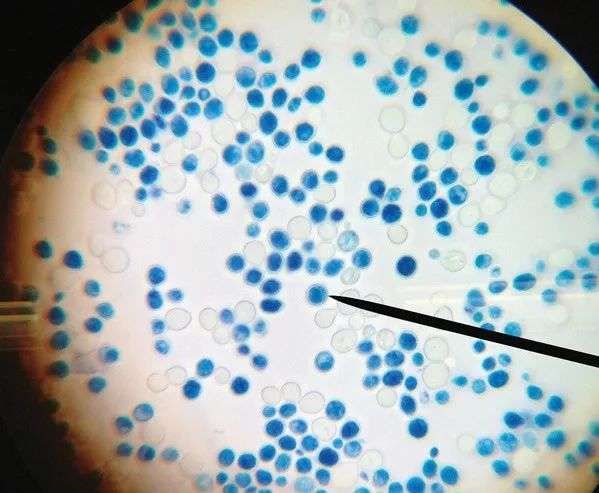

应用超过40年,酵母成分如何成为后生元护肤代表?
编者按:本文来自微信公众号“聚美丽”(ID:jumeili-cn),作者:诗诗,36氪经授权发布。
随着人们对皮肤微观世界的不断探究与了解,逐步发现微生态与各类皮肤问题乃至皮肤疾病之间存在的联系后,微生态护肤的理念日渐备受推崇。在聚美丽往期文章《关于皮肤微生态的护肤研究,只是另一个好听的故事吗?》中,我们对皮肤问题研究和微生态护肤的技术应用进行了概述。
在化妆品原料层面,对应微生态护肤的原料成分主要有:益生菌、益生元、后生元等3个类别,各大跨国公司也都推出了不同的产品。出于让行业从各个维度更全面了解皮肤微生态与护肤应用的初心,成分特辑将推出与微生态相关的系列文章,本期特辑就将重点介绍其中的一个大类:酵母菌。
在益生菌领域,酵母菌能够经过生命活动产生大量有益皮肤健康的营养物质,是目前应用最广泛的菌种之一。酵母菌和人类的基因组高度重叠,同源率高达23%,因此与人体皮肤具有更高的亲和性。同时,酵母也作为经典蛋白质组表达体系,被大量用于人源蛋白质的合成。
△显微镜下的酵母菌(图片来源于网络)
酵母菌在护肤品中的应用很广,然而它的发展过程存在不少分歧和误区。比如,雅诗兰黛、兰蔻等国际大牌常用的二裂酵母成分,虽然名字中带有酵母,但本身并非是酵母菌属,而是乳酸菌属中的双歧杆菌,这是翻译过程中的一个小插曲。再如,像“酵素”这类名称的产品,其实跟酵母八竿子都打不着。
此外,酵母护肤还诞生了某些“畸形概念”。比如,2013年,女星张庭创建的护肤品牌TST在微商界走红,一时之间,“活酵母”的概念迅速流行起来,关注度极高。但是,国家关于化妆品的相关法规里明确规定过,任何化妆品里都不允许添加“活菌”。

△TST活酵母新生面膜乳
北京清华长庚医院皮肤科医生赵邑曾经表示,从酵母中提取的一些元素,对护肤是有益的,但并不是那么简单,拿来就能用,其可靠性和安全性都需要有官方认证。
那么这些主打“酵母”的护肤品,通常添加的都是什么呢?
一般护肤品中的酵母成分并非是单纯添加的酵母菌种,而是经过生命活动的酵母菌衍生物。因此,虽然酵母菌本身属于一种有益菌,但酵母护肤成分其实归属于益生元或后生元类别,这也是酵母菌与乳酸菌的明显不同之处。
益生菌经加工处理后的成分,包括菌体与代谢产物,统称为后生元,是未来微生态护肤的一大发展方向。而作为一类益生菌,酵母菌的衍生物随之受到高度重视,由此发展出多种多样的酵母成分,且表现出独特的优势。
那么,酵母成分具体的功效如何体现?目前的应用和研究现状是怎样的?下文将对这些问题进行探讨。
酵母菌:生物转化的加工厂,可促进代谢
酵母菌是一种古老的真菌细胞,目前已知的酵母菌株有1000多种。日常生活中我们对于酵母菌的认知,在于其可以通过发酵来酿酒或制作面包。值得一提的是,在7000年前古埃及人已经会利用酵母来酿酒了。
在护肤领域,酵母菌的应用也早有先例。例如,上千年前,古巴比伦人就开始利用啤酒酵母帮助肌肤伤口的愈合,希腊妇女也常用酿酒发酵产生的泡沫擦洗身体和脸部,保持皮肤的健康美丽。直到17世纪列文虎克从显微镜中发现酵母的存在,人们才展开酵母的工业应用和研究。
这种微生物与调理皮肤之间有什么联系?我们可以把酵母菌理解成为一个加工厂,它在进行生命代谢活动过程中,会对其生长环境中,甚至是自身所含的营养物质进行“加工”,从而转化出更有利于皮肤健康的成分。
因此,护肤品中的酵母衍生物,一般分为两大类,即酵母菌发酵滤液和酵母菌溶胞物/提取物。前者种类庞杂,通过不同的酵母,在不同来源的外界营养条件下发酵而得到有护肤价值的成分;而后者是通过破坏酵母细胞壁,过滤其细胞液,从而提取到有效成分。从本质上看,这两者成分中,最终作用于皮肤的有效物质,往往是一些容易吸收的氨基酸、维生素、多糖、核酸和矿物质等活性物。
比如,有研究表明,酵母菌中含有抗氧化成分超氧岐化酶(SOD),而通过不同的发酵或提取方式,如葡萄酵母发酵、酵母破壁等,可以得到微生物来源的SOD。研究人员表示,相比于传统的动物血液提取方式,通过微生物提取SOD可以实现量产,降低生产成本,同时得到的SOD性质更稳定,易储存。
此外,酵母成分中也包含蛋白质和多肽类,因此酵母提取物可作为抗衰老和美白功效成分来使用。2020年,北京工商大学的付豪等人用反复冻融法结合超声波破碎法,分离提取了三种不同酿酒酵母蛋白,对比了这三种酵母蛋白的自由基清除效果,并通过酶解得到了酵母来源的多肽成分。结果显示,三种酿酒酵母上清蛋白都具有很好的清除DPPH的能力,2.6g/L左右的浓度其清除率能达到72%左右,同时,3.5g/L左右浓度的酿酒多肽,酪氨酸酶抑制率可达到50%左右,与1g/L的熊果苷相近。

△截图自相关文献
从整体功效上看,两类酵母成分都能够促进代谢,具有修复皮肤、改善粗糙、抗衰老和美白的作用,而且现有的很多实验也都验证了酵母的这些护肤作用。2009年,国外的志愿者测试结果表明,使用含酵母菌成分的护肤品能够显著改善皮肤粗糙度和提亮肤色。2011年,日本科学家也通过小鼠实验,发现酵母菌成分能够降低黑色素,改善皮肤过敏现象。
酵母衍生物成分和原料的研发,以后生元为主
随着消费者对微生态护肤的关注热度持续升温,行业上游从原料公司到品牌企业都在加大研发力度。在产品应用上,酵母的运用还是比较成熟的。比如,宝洁旗下的SK-II凭借着专利成分Pitera经久不衰,其明星产品护肤精华露(神仙水)不仅是以酵母为主要成分的代表护肤品,更是整个微生态护肤领域的代表性产品之一。
半乳糖酵母样菌发酵滤液
大多数人可能不清楚半乳糖酵母样菌发酵产物是什么,但提到Pitera,就几乎是人尽皆知。SK-II自1980年进入中国市场以来,其品牌销量,尤其是神仙水的销量经久不衰。在这款产品的成分表中,共七种成分,其中只有一种活性成分,即半乳糖酵母样菌发酵产物。

Pitera其实就是半乳糖酵母样菌发酵滤液,是由一种覆膜孢酵母属的特殊酵母在发酵过程中提炼出各种活性成分的混合物。据Pitera专利成分的创建人柏山正义发布的测定值显示,两倍浓缩Pitera的含水量达到98.7%,剩余1.3%为其他成分,其中含有0.6%的酸、微量糖类和氨基酸,以及一些矿物质。该成分的pH值偏酸,对于皮肤有不错的延缓衰老、增强光泽和美白的效果。
Pitera的高渗透性和功效作用受到一众称赞,但要谈“酵母成分的天花板”还是为时过早,其他许多未知或者已知的酵母成分,显现的功效也都不差。而且,由于Pitera容易渗透皮肤,对皮肤敏感人群并不适用。
巴斯夫、帝斯曼等推出的酵母类护肤原料
2017年,德国化工企业巴斯夫推出了第一款能够重新平衡皮肤微生态系统的活性成分:Relipidium™,该成分属于一种后生元,由酵母水解蛋白以及保湿剂丁二醇、1,2戊二醇组成。从对皮肤微生物群的体内研究结果看,它能够刺激表皮中脂质的合成,从而加速屏障修复和加强皮肤的防御,同时具有良好的保湿效果。
巴斯夫通过体内实验证明,Relipidium™可显著提高皮肤含水量12%,在两周内。干燥皮肤的生态失调得到了平衡,皮肤常驻菌表皮葡萄球菌与皮肤致病菌金黄色葡萄球菌的比值增加了2.3倍。
荷兰帝斯曼也曾推出后生元化妆品原料OXY 229 PF,INCI名为酵母菌溶胞物、缬氨酸、苏氨酸、谷氨酸、 甘氨酸、琥珀酸二钠。该原料筛选了一种贝克酵母菌株。据称,其包含线粒体呼吸激活器,能够将氧气吸收量提高 750%,诱导细胞存活率高达 10%,细胞周转活动增加 25%。
为了研究微生物对皮肤的影响,帝斯曼的科学家在一项研究中鉴定了200多种不同的细菌,发现克氏棒杆菌是导致面部发红的新靶点。而OXY 229 PF可以减少克氏棒杆菌水平,从而有效控制面部发红的症状,而且能够降低皮脂水平,起到抗衰老的功效。

△OXY 229 PF能降低克氏棒杆菌的水平
国内企业,比如全丽、伽蓝等公司同样对酵母成分进行了持续研究。全丽推出银耳、燕麦、积雪草等一系列的酵母发酵提取物;伽蓝甚至将酵母菌株送上太空,筛选出更强活力的“太空酵母”。
从现有的整体研发趋势看,酵母护肤成分大多为后生元。这些由品牌、厂商推出的专利酵母成分或者原料,都经过相应的实验研究,并且公开了现有的资料和数据,往往具有一定的应用优势。
“酵母护肤品”的正确打开方式其实是……
英敏特数据显示,在全球范围中,亚太地区是发酵护肤成分使用最活跃的地区,2018年发酵护肤产品全球占比约43%,在2016年到2018年期间,欧美地区的发酵护肤产品占比也在逐年增长,或许微生态护肤将迎来属于后生元的时代。
通过酵母发酵得到的后生元成分,在功效表达、渗透能力等方面得到了提升,但发酵产物通常伴随着特殊气味,因此需要通过一些方式,比如添加气味掩蔽剂来弥补不足。为了协同增效,酵母成分也适合复配其他功效成分,包括其他微生物成分。
2018年,丸美在日本上市了高端护肤线MARUBI TOKYO,该品牌推出的小酒瓶精华中就添加了一种专利成分酒魂酵母SakoulTM,浓度达到30%。品牌官方数据显示,这一酵母精粹提取成分比发酵产物溶胞物抗衰老能力强三倍,内含小分子氨基酸,可以刺激胶原蛋白的合成。此外,小酒瓶精华中还复配了强抗氧化力的富勒烯和野大豆胚芽提取物,气味呈现出淡雅的酒香。

△丸美东京MARUBI TOKYO小酒瓶精华
Fresh馥蕾诗的红茶酵母精华水,主打抵抗城市污染、提亮肤色和抗衰老。其配方精简,选择了共26种成分,大多数为食品级别的成分,其中最主要的就是酵母发酵的红茶。该发酵成分含有茶多酚、维生素B群、氨基酸和矿物质等,排在了产品成分表的第二位,具有较强的抗氧化性。
根据Fresh公布的临床实验结果,使用该产品28天后,肤色、细纹、毛孔、保湿等方面都得到了改善,同时,通过改善皮肤微生态环境可以抵御外界污染。

△Fresh馥蕾诗红茶酵母精华水
除了发酵成分之外,也有一些品牌选择了酵母溶胞物作为活性成分,比如OLAY熬夜霜,其中添加了一种香槟酵母发酵溶胞提取物。该成分是宝洁委托一家法国原料商研究出来的,在单纯酵母发酵的基础上进行二次发酵,由于价格昂贵被称为“黄金酵母”,SK-II鎏金系列中也使用了这一成分。据称该成分能够促进皮肤细胞代谢,促进胶原蛋白的生成。

△OLAY熬夜霜
益生菌、后生元护肤的应用,是基于我们对皮肤微生态的认知加深,逐渐升级迭代的。在一定程度上,SK-II等品牌首先将酵母菌运用到护肤品中,引起了行业对以酵母菌为代表的益生菌领域的注意和重视。
虽然在后续的发展中,不乏一些误解的出现与概念性的产物,让消费者对酵母的认知或许不是很清晰。但不可否认的是,酵母来源的后生元成分应用前景良好,国内外对此的相关研究持续在推进。如前文所言,在种类上,酵母菌株有1000多种,不同的类型、不同的营养环境,如何起到更好的皮肤护理效果,这个探索的领域还十分广阔。
相关推荐
应用超过40年,酵母成分如何成为后生元护肤代表?
切入特定孕妈群体“小分类”,「肌肤芝音」要逐步拓展“健康护肤”大市场
“成分护肤”的风还会刮多久?华熙生物旗下「Bio-MESO」认为回归效果和品牌是本质
《自然》杂志论文:转基因酵母合成大麻素,产大麻如同酿啤酒
小众护肤品牌如何讲故事
成分护肤需求升级,「神秘博士」认为效果+创新工艺是有效成分护肤品牌的机会
美妆护肤品牌创业,如何更进一步
宝洁和强生护肤品研发出身,三亩大叔如何靠“成分”拿下高知女性?
抗氧成分党风盛行,「修丽可」用“O+O+O”打通诊所和居家护肤场景
围绕工业大麻CBD+成分,「2XY」专做无性别差异的护肤品
网址: 应用超过40年,酵母成分如何成为后生元护肤代表? http://www.xishuta.cn/newsview44749.html
推荐科技快讯
- 1问界商标转让释放信号:赛力斯 95792
- 2报告:抖音海外版下载量突破1 25736
- 3人类唯一的出路:变成人工智能 25175
- 4人类唯一的出路: 变成人工智 24611
- 5移动办公如何高效?谷歌研究了 24309
- 6华为 nova14深度评测: 13155
- 7滴滴出行被投诉价格操纵,网约 11888
- 82023年起,银行存取款迎来 10774
- 9五一来了,大数据杀熟又想来, 9794
- 10手机中存在一个监听开关,你关 9519
